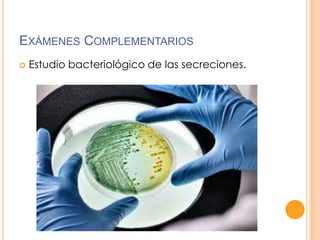
EXÁMENES COMPLEMENTARIOS


Estudio bacteriológico de las secreciones.

El documento resume el examen físico de la cabeza, dividiéndolo en examen en conjunto y examen por regiones. En el examen en conjunto se evalúan la posición, volumen, forma y movimientos de la cabeza. En el examen por regiones se evalúan específicamente el cuero cabelludo, la frente, los ojos, la nariz, la boca, la faringe y laringe y el aparato auditivo.